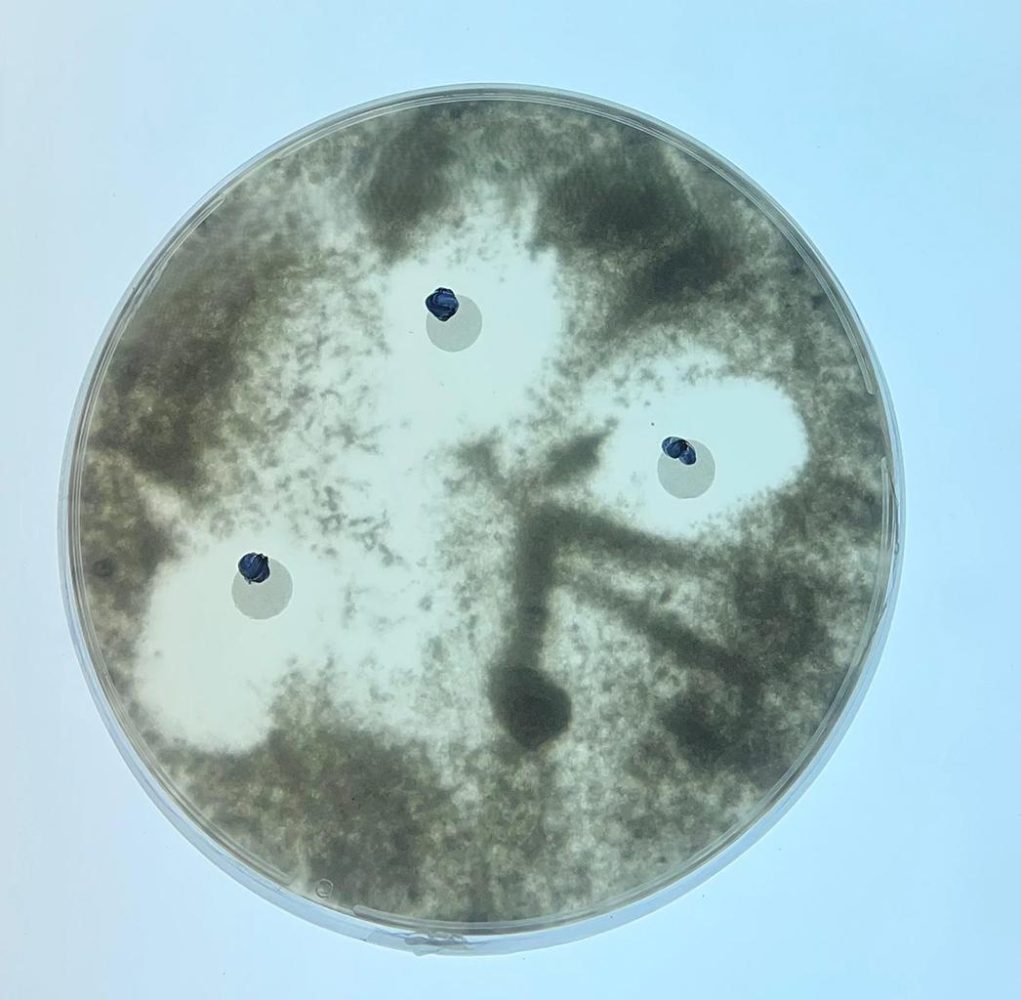

Un prometedor hallazgo anota la ciencia nacional y la fruticultura del país, sector que representa entre el 2 y 3% del Producto Interno Bruto (PIB). Se trata de microorganismos hallados en el desierto de Atacama con propiedades para retrasar la maduración de la fruta y evitar la propagación de hongos en ella.
El tiempo es un factor determinante para el éxito de la exportación de fruta, debido a que sobrepasar el periodo de traslado estipulado, el producto puede experimentar variaciones negativas en su sabor, deshidratarse y verse expuesto a hongos, entre otros riesgos.
Es en virtud de este factor que los exportadores de cerezas, por ejemplo, han optado por servicios logísticos como el Cherry Express, que promete reducir a 23 días los 30 que demoraba en promedio el envío marítimo a China.
Para anticiparse a los riesgos que conlleva el tiempo de traslado, los exportadores se valen de fungicidas para prevenir la aparición de hongos. Sin embargo, estos pueden dejar residuos en la fruta que pueden ser nocivos para el ser humano si es que superan los límites permitidos internacionalmente. Fue en parte por esta situación que investigadores de la Universidad de Chile desarrollaron un mecanismo para proteger la fruta, basado en estos organismos del desierto de Atacama.
Un recubrimiento comestible
“En este proyecto trabajamos con bacterias extremófilas (habitan en condiciones extremas) aisladas previamente de la rizosfera (zona del suelo asociada a las raíces) de la planta de lupino del Desierto de Atacama. A partir de estas muestras ambientales, se evaluaron en el laboratorio las que presentaran mejor actividad antifúngica”, explica en diálogo con EL DÍNAMO el investigador postdoctoral Diego Sandoval.
El doctor en Ciencias explica que no buscan replicar el hábitat de este microorganismo -bastante diferente a un entorno refrigerado- sino que incorporar sus moléculas a un recubrimiento comestible, cuyos componentes son reconocidos como seguros para uso alimentario.

Por ahora, este recubrimiento que contiene las moléculas provenientes del desierto está siendo aplicado principalmente en paltas, cítricos y manzanas, las frutas que más sufren por hongos postcosecha durante el almacenamiento y transporte.
No obstante, aún hay desafíos para que esta formulación pueda testearse y ser incorporada a una cadena exportadora. “Uno de los desafíos es lograr que una formulación sea estable, reproducible y fácil de aplicar en condiciones reales de postcosecha. Otro es escalar la producción de los extractos o de moléculas activas, validarlos en más ensayos y luego avanzar hacia una certificación y la transferencia a la industria”, detalla Sandoval.

El desierto se erige como destino de interés científico
El Dr. Juan Asenjo, Premio Nacional de Ciencias Aplicadas y uno de los responsables del proyectos junto a la doctora Bárbara Andrews, profundiza en conversación con EL DÍNAMO en el potencial del desierto más árido del mundo. “Tenemos una gran colección, llevamos años encontrando cepas en el desierto y en la fosa de Atacama, a 8.000 metros de profundidad”, explica el profesor titular del Departamento de Ingeniería Química, Biotecnología y Materiales (DIQBM) de la Universidad de Chile.
“Algunos les hemos puesto nombres, incluso mis colegas ingleses a uno le pusieron Streptomyces Asenjoni, así que ahora me puedo ir tranquilo”, bromea.
El académico explica, además, la excepcionalidad de este lugar: “Si bien este desierto no es muy grande comparado con otros, como el de Sahara, es muy seco, muy árido y tiene altísima radiación. Por eso la chance de encontrar ahí microorganismos que hagan cosas especiales es más alta que en otros lados”.
“Hemos encontrado enzimas que se usan para degradar plástico, del mismo desierto y de la fosa de Atacama. Hay potencial de desarrollar antibióticos, bacterias con potencial anticancerígeno, antioxidantes para alargar la vida del ser humano“, revela.
Varios de los posibles usos de los microorganismos del desierto de Atacama aún están en estudio. El que promete optimizar el traslado de fruta, tal como mencionaba el investigador Diego Sandoval, aún debe escalar su producción. “El problema es que estos microorganismos realmente en el desierto no los usan, entonces se producen en cantidades muy pequeñas. Y hay que hacer un modelo a escala genómica del metabolismo, que tiene más de mil reacciones, de todo lo que pasa dentro del microorganismo para ver cómo aumentar la cantidad”, coincide Asenjo.